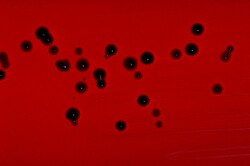

Chromobacterium
| Chromobacterium | |
|---|---|
| |
| Blood agar plate culture of Chromobacterium violaceum | |
| Scientific classification | |
| Domain: | Bacteria |
| Kingdom: | Pseudomonadati |
| Phylum: | Pseudomonadota |
| Class: | Betaproteobacteria |
| Order: | Neisseriales |
| Family: | Neisseriaceae |
| Genus: | Bergonzini 1880[1] |
| Type species | |
| Chromobacterium violaceum[1] | |
| Species | |
|
C. alkanivorans[1] | |
Chromobacterium is a genus of Gram-negative rod-shaped bacteria.[3]: 279 Currently, eleven species within the genus are known, two of those are Chromobacterium violaceum and Chromobacterium subtsugae;[4] the latter was discovered by scientists at the Agricultural Research Service in Beltsville, Maryland.[4]
References
- ^ a b c d e f g h i j k l Parte, A.C. "Chromobacterium". LPSN.
- ^ Blackburn, Michael B.; Farrar, Robert R.; Sparks, Michael E.; Kuhar, Daniel; Mowry, Joseph D.; Mitchell, Ashaki; Gundersen-Rindal, Dawn E. (2019). "Chromobacterium phragmitis sp. nov., isolated from estuarine marshes". International Journal of Systematic and Evolutionary Microbiology. 69 (9): 2681–2686. doi:10.1099/ijsem.0.003508. PMID 31199223.
- ^ James, William D.; Berger, Timothy G.; et al. (2006). Andrews' Diseases of the Skin: Clinical Dermatology. Saunders Elsevier. ISBN 978-0-7216-2921-6.
- ^ a b Martin, Phyllis A. W.; Gundersen-Rindal, Dawn; Blackburn, Michael; Buyer, Jeffrey (May 2007). "Chromobacterium subtsugae sp. nov., a betaproteobacterium toxic to Colorado potato beetle and other insect pests". International Journal of Systematic and Evolutionary Microbiology. 57 (5): 993–999. doi:10.1099/ijs.0.64611-0. PMID 17473247.